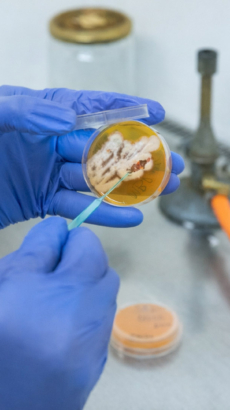
rufin

„Chuť podnikat převálcovala strach.“ Příběhy zakladatelů, kterým správný pit-stop ušetřil roky omylů
Náročná rozhodnutí nelze dělat ve vleku každodenních povinností. Naštěstí jsou tu parťáci, kteří potřebný pit-stop umí obstarat. Pro majitele zavedených firem, zakladatele startupů nebo vědce či studenty, kteří o vlastním byznysu teprve sní.
Spousta z nás sedí v open space kanceláři a sní o vlastním projektu. Jiní už pár let řídí vlastní firmu. Na cestě k úspěchu nás ale brzdí stejná věc – žijeme zaseknutí v operativě. Není čas ani prostor udělat krok zpět, abychom získali širší perspektivu a podívali se dál do budoucnosti. Úspěšného foundera přitom neodlišuje genialita nápadu, ale právě schopnost a vůle vystoupit ze zajetých kolejí a dělat důležitá rozhodnutí.
Čísla mluví jasně. V Česku sice vznikají nové firmy rekordním tempem a ve startupech už pracuje přes 160 tisíc Čechů, ale nejen evropské státy nám v podnikatelském nadšení utíkají. V počtu startupů na obyvatele jsme pod průměrem EU a každý třetí startup dokonce zvažuje, zda by se mu nevyplatilo přesídlit. Proč? Jako důvody ve výzkumu webu Czech Startups uváděly nejčastěji daňové zatížení, problematiku pracovněprávních vztahů a nedostatek kapitálu.
Podnikání je divoký závod. Když jedete 24/7 na plný plyn, těžko si všimnete, že dochází palivo a máte sjeté gumy.
Středočeské inovační centrum (SIC) je přitom jednou z veřejných služeb, které se v Česku snaží zlepšovat podnikatelské prostředí a dát zakladatelům vše potřebné k tomu, aby jejich šance na úspěch byla co nejvyšší. Firmám v jakékoli fázi od malých až po středně velké nabízí tolik potřebný pit-stop. Podnikatelé tak mají šanci na chvíli zastavit, zatímco zkušení mentoři v roli mechaniků pomohou zkontrolovat motor (tedy podnikatelskou hantýrkou byznys model). Případně doplní chybějící kontakty (networking) či finance (fundraising) a připravený závodník může zpět na trať, kde má větší šanci na úspěch.
Jsi z podnikatelského těsta?
Otestuj svůj mindset. Za pár minut zjistíš, jestli jsi vizionář, perfekcionista, nebo dříč v zajetých kolejích a jaký potřebuješ pit-stop.

Každý, kdo má v hlavě nápad a stojí na úplném začátku, nepotřebuje hned pálit miliony. Mnohem lepší start může být skrze startovací program, ve kterém začínající podnikatel či podnikatelka dostane zcela zdarma 15 hodin času se špičkovým mentorem vybraným na míru jeho nebo jejímu nápadu. Čas, klid a zkušený parťák šetří začínajícím podnikatelům roky drahého tápání a slepých uliček, těm zkušeným zase otevírá dveře na nové trhy a k novým zákazníkům.
Začni podnikat a hoď mýty za hlavu
Nezkušení zakladatelé mají tendenci se schovávat za klasické výmluvy a mýty. První z nich? „Do začátku potřebuju miliony.“ Omyl. K nastartování podnikání není potřeba obří investice. Nutnou podmínkou je schopnost se umět včas rozhodnout, zvalidovat produkt vůči skutečným potřebám zákazníků. Finance na škálování ověřeného produktu už potom nebývá velký problém sehnat.
Druhý mýtus tvrdí, že bez pražské adresy nebo letenky do Silicon Valley to nejde. Realita? Středočeský kraj nabízí vhodné podmínky pro podnikání, výrobu i výzkum. V kraji působí výzkumné organizace i technologické firmy s kvalifikovanými lidmi. A blízkost Prahy je vždy výhodou.
Místo produktového fetišismu řešte raději potřeby zákazníka
Pavel Jovanovič vede Středočeské inovační centrum, veřejnou agenturu podporující startupy a malé i střední podniky ve Středočeském kraji. Podle jeho zkušeností se stovkou projektů ročně bývají úspěšnější ti podnikatelé, kteří dobře chápou potřeby lidí, pro které svůj produkt nebo službu vytvářejí. Proč se v Česku stále bojíme neúspěchu?
A do třetice ještě jeden otřepaný mýtus: „Potřebuji naprosto unikátní nápad.“ Vůbec ne. Není potřeba držet patent na novou chemickou sloučeninu. Často stačí umět naslouchat trhu a vymyslet třeba jen to, jak lokální výrobu zefektivnit o 20 procent úplně obyčejnou digitalizací. Zákazník nehledá genialitu, ale v první řadě řešení svých reálných problémů. A právě nalezení tzv. original insight (originálního vhledu) do situace zákazníka a schopnost jej transformovat do produktu je to, co rozhoduje o tom, zda bude firma úspěšná.
Podnikatelská cesta je závod na náročné trati

Gumy, jindy natankovat. Co firma to jiný pit-stop
Čeští vědci umí dosáhnout špičkových vědeckých výsledků, často je ale už neumí „světově“ prodat. Potřebují proto propojovatele mezi laboratoří, investorem a dravým světem byznysu. Přesně takovou pomoc SIC nabízí a důkazem, že to funguje, je například firma TechTest. Její zakladatelé v čele s Petrem Cháberou vyvinuli právě v univerzitním prostředí unikátní technologii Recognoil, která zvládá detekovat různé nečistoty na kovových površích. Dnes jejich řešení používá SpaceX pro své vesmírné programy i Cartier ve výrobě těch nejdražších šperků.
„Když získáte první prestižní zákazníky, váš původně nadšenecký projekt rázem dospěje. Správně nastavit myšlení všech spolumajitelů byla velká výzva,“ říká Petr Chábera, který TechTest založil s kolegy z ČVUT. Příběh TechTestu je zajímavým mementem toho, že i čistokrevný akademik může začít budovat globální byznys. Stačí mít k ruce experty na transfer technologií a růstové strategie: „I přes velmi pečlivé průzkumy trhu se nám zpočátku nedařilo plnit obchodní cíle. Kvůli specifickým produktům je náš sales proces velmi náročný a vyžadoval technicky erudovaný obchodní tým.“
Začínali jsme s pouhými 40 tisíci Kč, které měly vydržet několik měsíců. Bylo to naivní, ale chuť podnikat převálcovala všechny racionální obavy.
Podobně úspěšnou cestu z laboratoře na globální trh si prošla například středočeská firma SigutLabs, jejíž název zastínil úspěch jimi vyráběného remdesiviru, o kterém se během covidové pandemie mluvilo téměř bez přestávky. „V laboratoři má všechno svůj jasný řád. Přesně víte, jak připravit cílovou molekulu, a když něco nefunguje, víte, kde hledat odpovědi. Byznys je ale úplně jiný svět s nekonečným množstvím cest a zpočátku mi chyběla zkušenost, kam vlastně směřovat energii – zda dřív stavět web, nebo shánět klienty,“ říká Kryštof Šigut, zakladatel SigutLabs. Následovat by je brzy mohl nadějný projekt Galochrom s jejich inovativní technologií pro chromatografii.
Výborným příkladem, že špičková věda patří na trh, a ne do šuplíku, je také reprodukční bioložka Kateřina Komrsková. Se svým startupem Molecule 46 řeší klesající kvalitu spermií a globální problémy s neplodností. Její patentovaná technologie využívá magnet k rychlé a šetrné separaci zdravých spermií.
„Vědecky perfektní řešení samo o sobě nestačí. Pokud ho neumíte prodat a trefit timing, z laboratoře se k lidem nikdy nedostane,“ věří dnes už úspěšná podnikatelka. Zastávka v SIC Startup Akcelerátoru jí umožnila načerpat obchodní know-how a získat sebedůvěru pro komunikaci s prvními investory.
„Nejtěžší pro mě bylo změnit myšlení z akademického na podnikatelské. Věda je o absolutní preciznosti a dlouhodobém hledání pravdy, zatímco byznys vyžaduje rychlá rozhodnutí a práci s obrovskou nejistotou. Až když se naučíte mezi oběma světy balancovat, dokážete výsledky z laboratoře dostat skutečně k lidem,“ říká Komrsková.
Podnikatelský úspěch ale kromě odvážlivců z vědy a výzkumu může slavit i mladá generace a její nakažlivé odhodlání. Stačí dravost a kreativitu vhodně usměrnit v akceleračním programu. Příkladem může být projekt Knither, za kterým stojí designér Oldřich Voyta (34 let). Na 3D tiskárně úspěšně vytiskl například první české flexibilní boty.
Od trhu nedostáváte facky, ale budíčky. Změnit plán není prohra, je to strategie růstu.
Na jeho cestě byl zlomový už samotný impuls do SIC Akcelerátoru vůbec vstoupit. Paradoxně k němu nedošlo v zasedačce, ale neformálně nad sklenkou vína s člověkem, který Voytu správně nasměroval. Od té chvíle do sebe všechno začalo zapadat. „S každým dalším workshopem a diskuzí s mentory se obraz vyjasňoval. Je to právě ta komplexita programu, která zakladatele s každým setkáním posouvá o mílové kroky kupředu,“ věří Voyta, který v poslední době působí často po boku Nataliye Grimberg (30), se kterou propojuje módu s uměním, umělou inteligencí a udržitelností.
Dalším příkladem mladého podnikání jsou bratři Vojtěch a Ondřej Veverkovi (27 a 29), kteří vyvinuli ComboSki – hybridní lyže, sněžnice a nesmeky v jednom. SIC a jejich startupový akcelerátor jim pomohl překonat první tvrdé facky a najít místo na trhu.
Mentoři Knitheru i ComboSki pomohli zvýšit šance, že první kroky udělají správným směrem. Zakladatelům rady zkušenějších ušetřily roky zbytečných pokusů a omylů. Oba bratři v začátku nešťastně přišli o peníze vybrané v crowdfundingové kampani.
„Ztráta peněz z Kickstarteru se dala překonat. Tím nejtěžším rozhodnutím bylo opustit jistotu dobře placené práce a zjistit, kolik úsilí ve skutečnosti stojí produkt vůbec prodat a firmu dlouhodobě držet při životě,“ shodují se Vojtěch a Ondřej Veverkovi, kteří ComboSki založili v roce 2022.
Inovace v podání mladých startupistů v mikinách jsou jen jednou z mnoha příchutí podnikání. Pro rozvoj fungujících a zavedených firem, které nečekaně narazily na pomyslný strop, je změna mindsetu otázkou přežití. SIC středně velkým, tradičním i rodinným firmám nabízí program Platinn. „Pro lidi stojící v čele zavedených firem jsme partnerem, který jim poskytuje zázemí, aby se mohli osvobodit od setrvačnosti a vydali se tím správným směrem. V rozbouřených vodách dnešního byznysu, který ovlivňují stále četnější technologické a společenské změny, nelze stát na místě,“ dodává šéf SICu Pavel Jovanovič.
Krásným příkladem této partnerské pomoci je tradiční kladenská rodinná firma Beznoska, která funguje od roku 1992. Tento známý výrobce kloubních náhrad chytil v pravý čas druhý dech, masivně inovoval produktové portfolio a spolu s digitalizací výroby začal vyvíjet i systémy umožňující sledovat stav pacienta na dálku a lépe plánovat nebo kontrolovat léčbu ortopedických onemocnění.
Inovovat se dá doslova i z vesmíru, a to i v tradičních oborech. Příkladem je středočeská firma Varistar, která přináší takzvané chytré zemědělství. Využívá data ze satelitů k tvorbě detailních map výnosového potenciálu a s pomocí umělé inteligence řídí přesné dávkování hnojiv. Zastávka ve středočeském pit-stopu jim pomohla pokročilé technologie otestovat a začít škálovat, díky čemuž dnes jejich aplikace šetří přírodu i peníze více než dvěma stům farmářů.
Věděli jsme, že věci děláme dobře, ale chtěli jsme je dělat špičkově.
„Inovace pro nás nejsou nepřítelem tradice, ale jejím ochráncem. Pokud má firma prosperovat další desítky let, největším rizikem není chyba při zavádění novinky, ale to, že neuděláte vůbec nic. Do programu Platinn jsme nešli hasit požáry, ale brousit diamant. Mentoring nám potvrdil správnost našich procesů a pomohl s precizním laděním obchodu a digitální komunikace. Nešlo o bolestivé řezy, ale o strategické dotažení detailů, které v součtu dělají ten rozdíl mezi běžným podnikem a nedávným ziskem titulu Rodinná firma roku 2025,“ doplňuje Jan Semrád, spolumajitel a ředitel firmy Varistar.
Jako houby. Inovace také potřebují podhoubí
Tyto úspěšné firmy jsou sice skvělou vizitkou, ale na první pohled ukazují jen malou část toho, co se ve středočeském ekosystému doopravdy odehrává. Jejich společným jmenovatelem je často neviditelné podhoubí s názvem Innoforum, které funguje jako odrazový můstek pro další úspěšné příběhy. Podle šéfa SICu mohou inovace mít mnoho podob: „Skrývají se v chytřejším byznys modelu, špičkové uživatelské zkušenosti i silném příběhu značky.“
„Léta pečlivě budujeme komunitu, ve které se potkávají inovátoři z různých sfér. Za jediné setkání člověk získá inspiraci a osobní vazby, které by na LinkedInu budoval roky,“ vysvětluje Jovanovič, který má současně pocit, že v Česku mají podnikatelé tendenci produkty nekonečně vyvíjet k naprosté dokonalosti: „Skutečným klíčem k úspěchu je ale skvělý vhled do potřeb zákazníků a schopnost přetavit to do produktu firmy. To je směr, na který v SICu umíme začínající podnikatele navést.“
Komunita Innoforum pak funguje jako exkluzivní klub pro ty, kdo se chtějí stát součástí úspěšných byznysových projektů a nestát na místě. Na prvním místě je praktický networking s lidmi, kteří mají znalosti, zkušenosti a drive měnit věci k lepšímu. Polovinu sítě tvoří přímo zakladatelé a ředitelé firem. Zbytek inovačního ekosystému doplňují zkušení inovátoři, experti, výzkumníci a zástupci veřejných institucí i médií.
Pokud hledáte investora, potřebujete se učit od lídrů, toužíte nabrat kompetence nebo rovnou plánujete zahraniční expanzi, členství v takto aktivní komunitě je zkratkou k úspěchu. Nejde ani tak o přístup k trendům a inovacím jako o osobní vztahy, se kterými je jakékoli podnikání mnohem větší zábava.